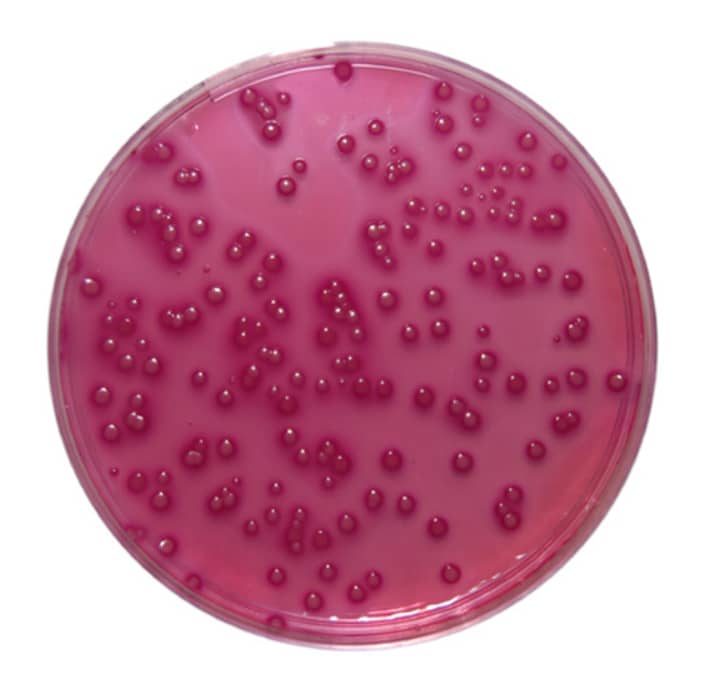
Violet Red Bile Glucose Agar

Artikel ini akan membahas tentang kegunaan Violet Red Bile Glucose Agar dan cara menggunakannya. Simak artikel ini sampai selesai.
Dalam bidang mikrobiologi pangan, farmasi, dan kesehatan, deteksi bakteri indikator sangat penting untuk memastikan keamanan produk. Salah satu kelompok bakteri yang sering diuji adalah Enterobacteriaceae, karena kelompok ini mencakup banyak spesies patogen. Untuk mendukung proses identifikasi, digunakan media kultur yang spesifik. Violet Red Bile Glucose Agar (VRBGA) menjadi pilihan tepat karena mampu menyeleksi bakteri Enterobacteriaceae sekaligus membedakannya berdasarkan fermentasi glukosa.
APA ITU VIOLET RED BILE GLUCOSE AGAR?
Violet Red Bile Glucose Agar adalah media kultur selektif diferensial yang diformulasikan khusus untuk mengisolasi dan menghitung bakteri Enterobacteriaceae dari berbagai sampel. Media ini mengandung kristal violet dan garam empedu yang menghambat pertumbuhan bakteri Gram-positif. Selain itu, adanya glukosa sebagai sumber karbohidrat serta indikator pH memungkinkan diferensiasi koloni berdasarkan fermentasi. Koloni Enterobacteriaceae biasanya tampak merah hingga ungu tua dengan zona presipitasi di sekelilingnya.
KEGUNAAN VIOLET RED BILE GLUCOSE AGAR
Penggunaan VRBGA memiliki banyak manfaat, terutama dalam pengujian mikrobiologi. Berikut adalah beberapa kegunaannya:
Isolasi Enterobacteriaceae
Media ini menyeleksi pertumbuhan bakteri target dengan efektif.
Enumerasi bakteri indikator
Cocok digunakan dalam metode pour plate atau spread plate untuk menghitung jumlah koloni.
Pengujian keamanan pangan
Sering diaplikasikan pada produk susu, daging, air, dan makanan olahan.
Kontrol kualitas farmasi
Membantu mendeteksi adanya kontaminasi mikroba dalam produk farmasi.
Riset mikrobiologi
Berguna dalam penelitian terkait flora usus dan bakteri patogen enterik.
Baca juga: Prinsip Kerja Butlerbot W3
BAGAIMANA CARA MENGGUNAKANNYA?
Agar hasil uji mikrobiologi optimal, penggunaan VRBGA harus dengan prosedur yang benar. Berikut langkah-langkahnya:
Persiapan media
- Larutkan bubuk VRBGA sesuai instruksi produsen.
- Panaskan hingga homogen, lalu dinginkan hingga ±45–50°C.
Inokulasi sampel
- Campurkan sampel dengan media menggunakan metode pour plate, atau teteskan pada permukaan media menggunakan metode spread plate.
- Gunakan teknik aseptik untuk mencegah kontaminasi.
Inkubasi
- Inkubasi cawan pada suhu 35–37°C selama 18–24 jam.
- Amati pertumbuhan koloni dengan cermat.
Interpretasi hasil
- Koloni Enterobacteriaceae akan berwarna merah hingga ungu tua dengan zona presipitasi.
- Koloni non-fermenter biasanya tidak menunjukkan warna khas.
- Hitung jumlah koloni sesuai kebutuhan analisis.
Violet Red Bile Glucose Agar (VRBGA) merupakan media selektif diferensial yang sangat berguna untuk isolasi dan enumerasi Enterobacteriaceae. Dengan komposisi khusus yang menghambat bakteri Gram-positif dan memfasilitasi fermentasi glukosa, media ini terbukti efektif dalam mendukung pengujian keamanan pangan, farmasi, dan penelitian mikrobiologi. Oleh karena itu, pemanfaatannya sangat penting dalam memastikan kualitas serta keamanan produk yang beredar di pasaran.
Itulah pembahasan tentang kegunaan Violet Red Bile Glucose Agar dan cara menggunakannya. Semoga artikel ini dapat bermanfaat.
Sumber:
ifu-pow4200-rev-02-violet-red-bile-glucose-agar-vrbg.pdf (goldstandarddiagnostics.us)